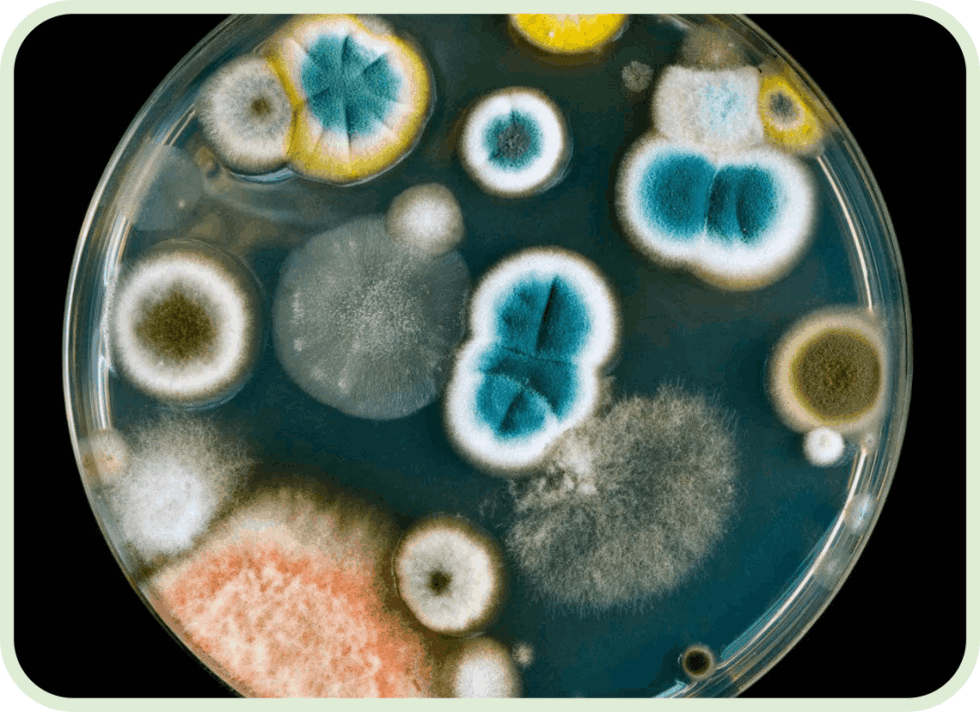
Mobirise

OLife®
Az OLife®, az olíva levél és körömvirág (Calendula Officinalis) infúzió az Evergreen Life exkluzív étrend-kiegészítője. Egy különleges, teljesen természetes gyártási folyamatnak köszönhetően az olíva fa leveleiben található hatóanyagok legmagasabb koncentrációját nyerjük ki.
✅ GLUTÉNMENTES
✅ VEGÁN BARÁT
✅ TERMÉSZETESEN ZSÍRMENTES
✅ TERMÉSZETESEN LAKTÓZMENTES
✅ NÖVÉNYI ÖSSZETEVŐK
EUR 29.99